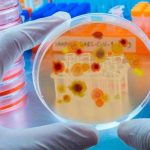
19 hongos que «amenazan la salud mundial» han sido publicados por la OMS La OMS publica la lista de hongos que amenazan la salud

Etiqueta: hongos
Hongos con sabor a carne: La nueva propuesta que conquista paladares en Estelí
Por más de 20 años, un hombre ha estudiado los diferentes tipos de hongos, pero ahora los ha convertido en uno de los platillos...
Turistas descubren hongos únicos y deliciosos en el corazón de Nicaragua
En invierno, muchas especies de hongos aparecen en diversos puntos de Nicaragua. Acompañamos a Hongos de Nicaragua en una caminata con un grupo de...
Ponele mente a ese granito: Prevención de enfermedades de la piel en Nicaragua
Con el Dr. Carlos Saldaña, médico especialista en dermatología del centro nacional de dermatología Francisco Soto Calderón; se hizo un programa en Estudio TN8...
¿Sabías que en Nicaragua existe un tour para recolección de hongos?
Se ha hecho bastante popular en Nicaragua, sobre todo para los amantes de la naturaleza y el aire libre, el Tour de Hongos. Este...
19 hongos que «amenazan la salud mundial» han sido publicados por la OMS
La primera lista de los 19 'patógenos prioritarios', han sido publicados por La Organización Mundial de la Salud (OMS). A su vez, los expertos...
Descubren que los hongos se comunican entre sí con un lenguaje propio
Un estudio de laboratorio en Reino Unido reveló que los hongos se comunican entre sí mediante un lenguaje particular, se trata de la emisión...
EE.UU: Hombre se inyecta té de hongos para la depresión y le crecen en...
Un insólito caso se presentó en Estados Unidos donde un hombre de 30 años trató de curar su depresión inyectándose un ‘té de hongos’...
Fabrican un «ataúd viviente» a partir de sistema de raíces de los hongos
En Países Bajos se realizó el primer funeral con un "ataúd viviente", que se descompondrá poco después del entierro y acelerará el proceso de...
¿Lavas tu ropa interior en la ducha? ¡Detente! Le haces un mal a tu...
Muchas mujeres suelen lavar su ropa interior mientras se duchan y, acto seguido, dejarla en el baño para que se seque allí. Aunque parezca...
Esta es la manera correcta de limpiar tu zona intima después de orinar
La limpieza inadecuada de la vagina después de orinar puede favorecer la proliferación de hongos y bacterias. Además, puede provocar picazón, irritación y dejar...